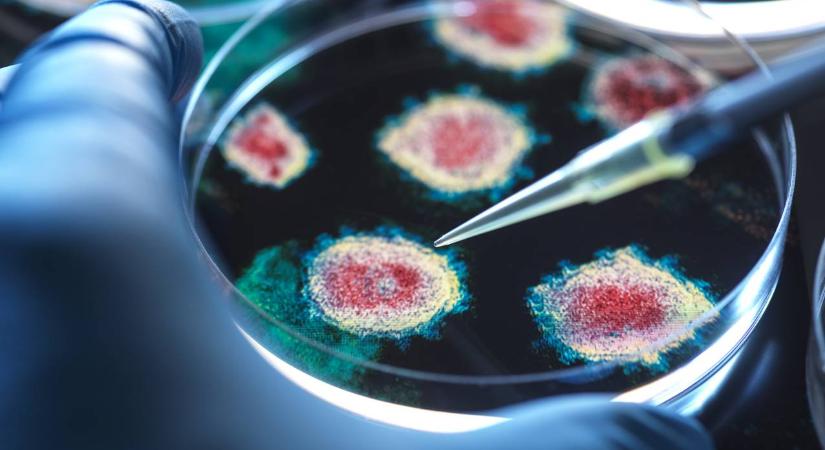
Legmagasabb fokozatú riasztás, karantén: három betegség terjed egyszerre járványszerűen Dél-Koreában

Legmagasabb fokozatú riasztás, karantén: három betegség terjed egyszerre járványszerűen Dél-Koreában
Dél-Koreában egyszerre három, állatokat érintő járvány tombol, a riasztási rendszer a legmagasabb fokozaton üzemel. A Mezőgazdasági, Élelmiszerügyi és Vidékügyi Minisztérium március végig meghosszabbította a karantén időszakát.
- Hirdetés -